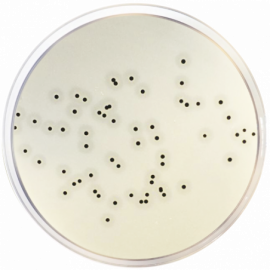
Baird Parker Agar Base Eur. Pharma

Baird Parker Agar Base is een selectief medium voor de isolatie en detectie van Staphylococcus aureus uit voedingsmiddelen en andere monsters. Lithiumchloride en kaliumtelluraat remmen ongewenste bacteriën, terwijl S. aureus herkenbare zwarte kolonies vormt. Geschikt voor routinematige kwaliteitscontrole en microbiologische analyses.
-
Merk
-
Merk artikelnummer
De chemicaliën in deze categorie zijn uitsluitend bedoeld voor professioneel laboratorium-, onderzoeks- of onderwijsgebruik door bevoegde organisaties en personen. Controleer vóór aankoop en toepassing altijd het meest recente veiligheidsinformatieblad (SDS), de lokale wet- en regelgeving (o.a. REACH, CLP, ADR) en de interne veiligheidsvoorschriften. Onjuist gebruik, opslag of verwijdering kan leiden tot ernstige gezondheids-, milieu- of materiële schade. Antonides aanvaardt geen aansprakelijkheid voor schade die voortvloeit uit onjuist of onveilig gebruik van de producten.